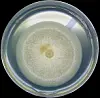

Evolusjon på 8 år
En studie av guppyfisken viser at evolusjon kan skje raskt, og at fisken kan tilegne seg egenskaper som øker overlevelsesraten i løpet av 30 generasjoner.
Denne artikkelen er over ti år gammel og kan inneholde utdatert informasjon.

Forskere fra University of California Riverside tok guppyfisk fra en elv og plasserte dem i en annen elv like ved.
De studerte de små akvariefiskene i 8 år og så hvordan de tilpasset seg et tryggere leveområde.
Studien er på trykk i julinummeret av tidsskriftet The American Naturalist.
Større og færre unger
Fiskene ble sluppet ut i den øvre delen av elven, over et lite fossefall hvor de var svært beskyttet mot rovdyr, men også hadde mindre mat.
Over rundt 30 guppygenerasjoner kunne forskerne se at fisken i området uten rovdyr hadde begynt å produsere større og færre avkom, mens ingen slik endring ble observert i den farligere delen av elva.
- Hunkjønn i områder med rovdyr investerer mer ressurser i reproduksjonen fordi de kanskje ikke får en ny sjanse senere, sier studiens forfatter Swanne Pamela Gordon i en pressemelding.

- I områder med færre rovdyr produseres det større avkom for hver reprodussjonssyklus, både fordi de er mer konkurransedyktige den første tiden, og fordi det vanligvis er mindre mat i disse områdene, sier hun.
Hun forteller at de også får færre avkom, og at det ikke skjer bare fordi hver av dem er større, men det koster guppyen mindre energi.
I et trygt leveområde som dette, men med litt lite mat, var det altså ikke noen vits for guppyen å bruke all sin energi på å få så mange avkom som mulig.
Større sjanse for å overleve
For å sjekke om de to guppygruppene virkelig hadde utviklet seg i en mer overlevelsesdyktig retning, introduserte forskerne nye fiskepopulasjoner i elva.
De hentet nye guppyer i en annen elv like ved og slapp de ut både ovenfor og nedenfor fossefallet som skilte de to gruppene fra hverandre.
Det ble fort klart at guppyene som hadde fått tilpasse seg over tid hadde mye større sjanse for å overleve, særlig som unger.
Småfisken fra den tilpassede populasjonen i den trygge delen av elva hadde en overlevelsesrate som lå mellom 54 og 59 prosent over de nyankomne.
- Dette viser at tilpasningsegnet forandring i et nytt miljø kan forbedre overlevelsesraten på under ti år, avslutter Gordon.
Kilde:
Swanne P. Gordon et. al., Adaptive Changes in Life History and Survival following a New Guppy Introduction, The American Naturalist, juli 2009